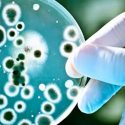

sobrevive
-

Científicos muestran cómo una estrella sobrevive tras ser devorada por agujero negro
¡Impresionante! Un grupo de científicos logró mostrar la imagen de una estrella mientras era devorada por un agujero negro. Y es que a cientos de…
-

¿Cuánto sobrevive el coronavirus en el papel? ¿y en tela? ¿y en cristal? ¿y en plástico?
Investigadores del Instituto Indio de Tecnología de Bombay (IIT Bombay), en India, han demostrado que una gota respiratoria permanece líquida durante un tiempo mucho más…
-
Las bacterias contradicen a Darwin: no sobrevive el más apto
Una nueva investigación microbiana en la Universidad de Copenhague sugiere que la «supervivencia del más cooperativo» supera la «supervivencia del más apto» para los grupos…
-

Una tortuga sobrevive tras extraerle una cuchara de plástico incrustada en su garganta [VIDEO]
El plástico vertido al mar se ha acumulado en una zona concreta del océano Pacífico oriental, entre California y Hawái, debido a los vertidos, las…






